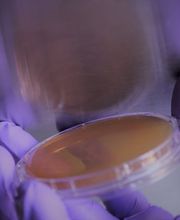
Biolytics Labor für biologische Analysen Bild 3
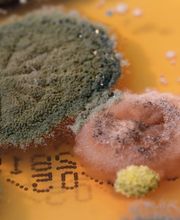
Biolytics Labor für biologische Analysen Bild 4

Schnell Zuverlässig Seit 2006
Biolytics Labor für biologische Analysen
Umweltanalyse · Forschung
0.0(0 Bewertungen)
Karschhauser Str. 23 A, 40699 Erkrath
+492104953740 (Telefon)
News & Angebote
Info
BiolytiQs analysiert Ihre Proben gründlich, zuverlässig und schnell. Wir führen mikrobiologische und mykologische Analysen von Luft-, Material- und Kontaktproben sowie Wasser und Klimaanlagen (RLT) durch. Wir informieren Sie ausführlich und konkret über vorhandene biologische Schadstoffe – damit Sie sicher wissen, woran Sie sind, und mit geeigneten Abhilfemaßnahmen wieder ein gesundes Raumklima schaffen können.
Öffnungszeiten
- Montag
- 08:00 bis 16:00
- Dienstag
- 08:00 bis 16:00
- Mittwoch
- 08:00 bis 16:00
- Donnerstag
- 08:00 bis 16:00
- Freitag
- 08:00 bis 16:00
- Samstag
- Geschlossen
- Sonntag
- Geschlossen
Medien

Map
Karschhauser Str. 23 A, 40699 Erkrath
Bewertungen
Nicht verifizierte Bewertungen0.0
(0 Bewertungen)


